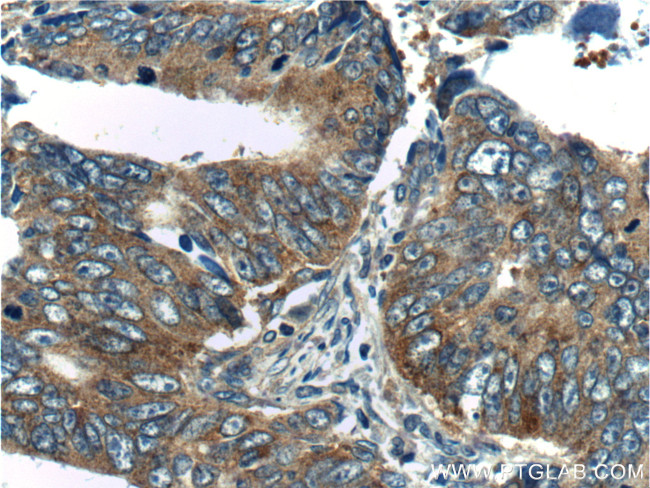
TPT1 Antibody in Immunohistochemistry (Paraffin) (IHC (P))

Search
Proteintech
TPT1 Polyclonal Antibody
{{$productOrderCtrl.translations['antibody.pdp.commerceCard.promotion.promotions']}}
{{$productOrderCtrl.translations['antibody.pdp.commerceCard.promotion.viewpromo']}}
{{$productOrderCtrl.translations['antibody.pdp.commerceCard.promotion.promocode']}}: {{promo.promoCode}} {{promo.promoTitle}} {{promo.promoDescription}}. {{$productOrderCtrl.translations['antibody.pdp.commerceCard.promotion.learnmore']}}
产品信息
10824-1-AP
种属反应
已发表种属
宿主/亚型
分类
类型
抗原
偶联物
形式
浓度
规格
纯化类型
保存液
内含物
保存条件
运输条件
产品详细信息
This antibody detected 22-25 kDa TPT1 in lysates. An additional band around 50 kDa can also be observed occasionally, possibly representing the dimer form of TPT1.
Immunogen sequence: MIIYRDLIS HDEMFSDIYK IREIADGLCL EVEGKMVSRT EGNIDDSLIG GNASAEGPEG EGTESTVITG VDIVMNHHLQ ETSFTKEAYK KYIKDYMKSI KGKLEEQRPE RVKPFMTGAA EQIKHILANF KNYQFFIGEN MNPDGMVALL DYREDGVTPY MIFFKDGLEM EKC (1-172 aa encoded by BC003352)
靶标信息
TPT1 (translationally controlled tumor protein 1) is a 23 kDa member of the TCTP family of calcium binding proteins. TPT1 is localized in the cytoplasm and widely expressed and serves as a transcriptional activator, calcium transporter, histamine inducer and antiapoptotic caspase 3 inhibitor. TPT1 is a cytokine-like molecule that causes the release of histamine, IL-4 and IL-13 from basophils as well as the secretion of IL-8 and a calcium response in eosinophils. TPT1 plays a pivotal role in allergic diseases and due to its wide distribution in brain, is thought to be involved in neurodegenerative disorders, such as Alzheimer's disease and Down syndrome.
仅用于科研。不用于诊断过程。未经明确授权不得转售。
生物信息学
蛋白别名: 21 kDa polypeptide; 21 kDa polypeptide under translational control; Fortilin; Histamine-releasing factor; HRF; Lens epithelial protein; p21; p23; TCTP; TPT1; translationally regulated transcript (21 kDa); Translationally-controlled tumor protein; unnamed protein product
基因别名: HRF; p02; p21; p23; TCTP; TPT1; Trt
UniProt ID: (Human) P13693, (Mouse) P63028, (Rat) P63029
Entrez Gene ID: (Human) 7178, (Mouse) 22070, (Rat) 116646